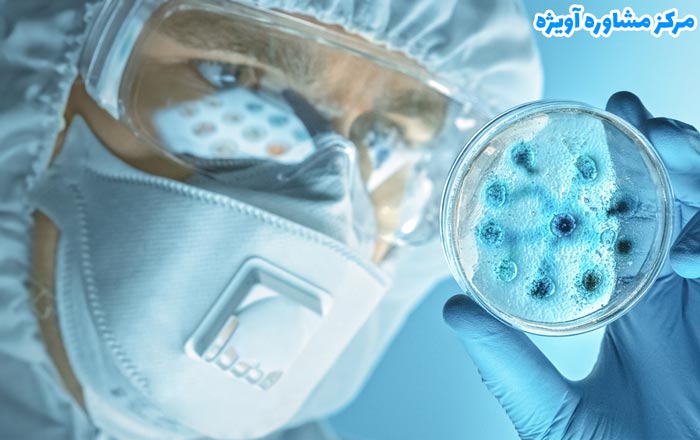

رشته میکروبیولوژی چیست؟ – معرفی کامل + بازار کار و آینده شغلی آن
3 سال پیش
- خواندن 2 دقیقه
رشته میکروبیولوژی، یکی از گرایشات پرطرفدار علوم تجربی است که این روزها در برخی کتب و سایت ها با نام زیست شناسی سلولی مولکولی هم نام برده می شود.
این رشته با هدف شناسایی جانداران میکروسکوپی و نقش آنها در زندگی انسانها ایجاد شده و عمده فعالیت محصلان این رشته به مطالعات میکروسکوپی میکروب و باکتری اختصاص می یابد.
داوطلبان با ورود به این رشته با مکانیزم آزمایشات مرتبط با میکروب شناسی و میکروارگانیسم ها (Microorganism) آشنا شده و سعی می کنند تا برای کنترل بیماری های عفونی روش های مختلف را ارزیابی و تحلیل نمایند.
همچنین برای تهیه و آزمایش دارو های جدید و ارائه نتایج پژوهش ها به افراد نیز می توانند پیشنهادات خود را ارائه دهند.
یک میکروبیولوژیست بایستی دارای ذهن جستجو گر بوده و دائما در حال کسب آگاهی از آخرین پیشرفت های علم میکروب شناسی جهان باشد.
میکروبیولوژیست ها بایستی دارای حافظه خوب، قدرت تجزیه و تحلیل لازم جهت بررسی مسائل مربوط به رشته میکروبیولوژی، و دقت بالا باشند.
افرادی در این رشته موفق خواهند شد، که صبر و حوصله زیادی داشته باشند، چرا که این رشته به بررسی ریزترین موجودات هستی می پردازد.
میکروبیولوژیست ها لازم است مهارت هایی همچون کار با نرم افزارهای آماری و کامپیوتری مرتبط با رشته خود را نیز کسب نمایند. چنانچه شما علاوه بر ویژگی های مذکور قابلیت رهبری یک تیم پژوهشی را نیز دارید، مطمئنا با تلاش و پشتکار در این رشته موفق خواهید شد.
با توجه به اینکه رشته ی میکروبیولوژی یک رشته ی علوم پایه است، امکان کارآفرینی در آن بسیار مهم است. تاسیس یک آزمایشگاه با همکاری متخصصان علوم آزمایشگاهی می تواند فکر خوبی باشد.
اما اگر از لحاظ سرمایه اولیه مشکلی وجود داشته باشد، تا رسیدن زمان مناسب می توانید در یکی از حوزه های صنعتی یا بالینی یا تحقیقاتی به عنوان ناظر یا کارشناس وارد بازار کار شوید.
البته مانند بسیاری از رشته های علوم پایه، برای اینکه اشتغال مناسبی در رشته ی میکروب شناسی داشته باشید، بهتر است برای ادامه تحصیل در مقاطع کارشناسی ارشد و دکتری برنامه ریزی داشته باشید.
خوشبختانه با پیشرفت علم و صنعت، رشته های علوم پایه مخصوصا رشته ی میکروبیولوژی فضای بسیار مناسبی برای کسب درآمد دارد.
البته مانند هر رشته ای و یا حتی بیشتر، لازم است علاقه و پشتکار خوبی داشته باشید. از میان تمامی فرصت های شغلی این رشته، کارآفرینی و ایجاد محیط شغلی شخصی می تواند یکی از بهترین بستر های کسب درامد باشد.

)

مشاهده نظرات بیشتر...